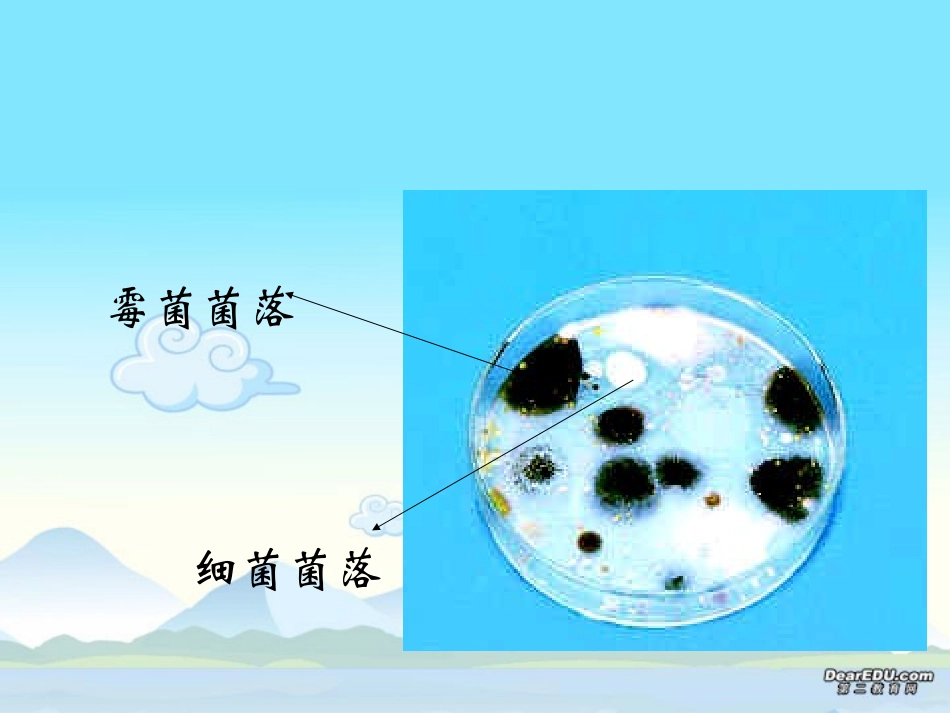
细菌和真菌的分布八年级生物第五单元第四章第一节课件示例 课件_第3页

第四章分布广泛的细菌和真菌第一节细菌和真菌的分布讨论提纲:1、细菌和真菌是什么样的
2、细菌和真菌在哪儿
3、你是怎样知道细菌和真菌的存在的
霉菌菌落细菌菌落探究:检验不同环境中的细菌和真菌问题:不同环境中都有细菌和真菌吗
哪种环境中更多一些
哪种环境中少一些
哪种环境中根本没有
探究思路:如何让孩子们知道手上有细菌或真菌
材料用具:两套装有培养基的培养皿(高温灭菌)、无菌棉棒、透明胶带、标签纸、放大镜如何制作培养基呢
提示:1、没有想好工作之前,不能打开培养皿
2、在标签纸上标出组别、实验日期、编号、将标签纸贴在培养皿的底面
3、为什么要有两套装培养基的培养皿,各有什么作用
4、在各自选定的环境中采集细菌和真菌
5、放在什么环境条件下培养
两套装培养基的培养皿都需要在同一环境下培养吗
6、设计好观察记录的表格,计划好观察的时间、次数
探究讨论:1、为什么培养用的培养皿和培养基,在接种前必须高温处理
为什么要用无菌棉棒
因为经高温处理后,可以将培养皿上、培养基内混有的细菌和真菌的孢子杀死,这样就排除了实验外其他环境的污染
因此,在实验前不要盲目打开培养皿,以防止细菌和真菌的孢子等落在培养基上
实验中用无菌棉棒的目的同样是为了防止棉棒上的微生物污染培养基
2、提示4相当于细菌、真菌一般培养方法中的哪一个步骤
提示4中的操作相当于一般培养方法中的接种步骤
3、通过各组的交流,你认为细菌和真菌的分布情况怎样
细菌和真菌几乎无处不在,但在不同环境中分布的多少不同,如手、硬币上附着的细菌和真菌较多
4、什么环境条件下不可能有细菌和真菌
在这个探究中,不可能有细菌和真菌的情况存在吗
经过严格的高温灭菌的环境中不可能有细菌和真菌的存在,如对照组的一套培养皿,因为对照组的培养皿经高温灭菌后一直处在密封状态
5、根据你的探究活动进行总结:细菌和真菌的生活必须具有哪